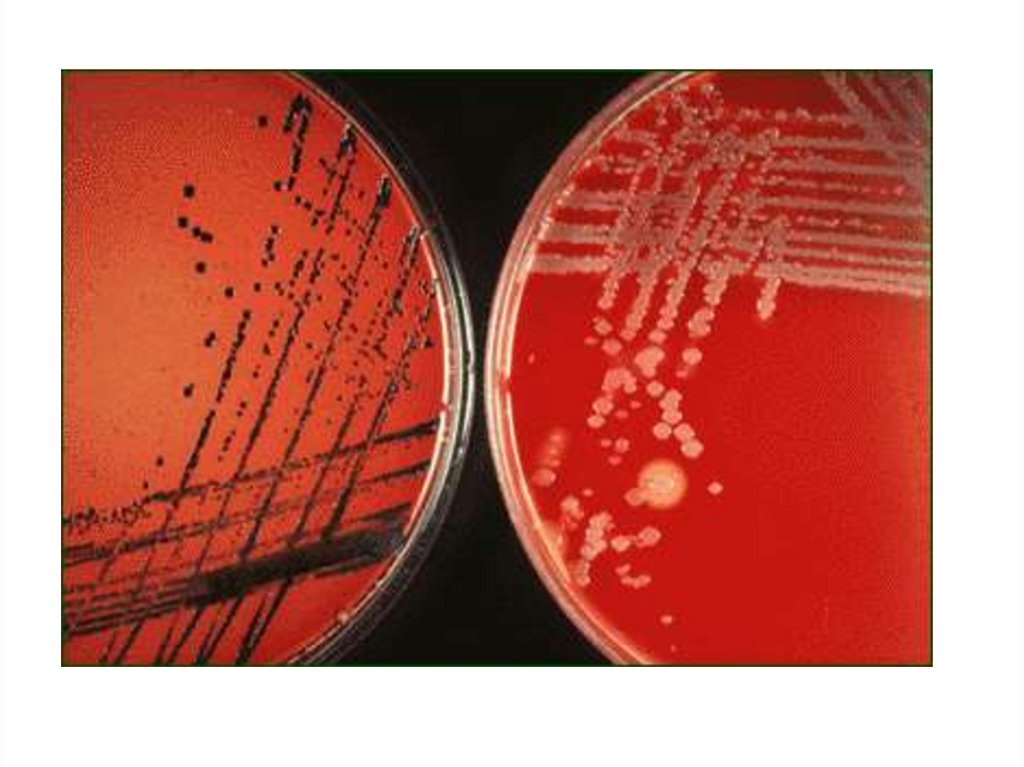
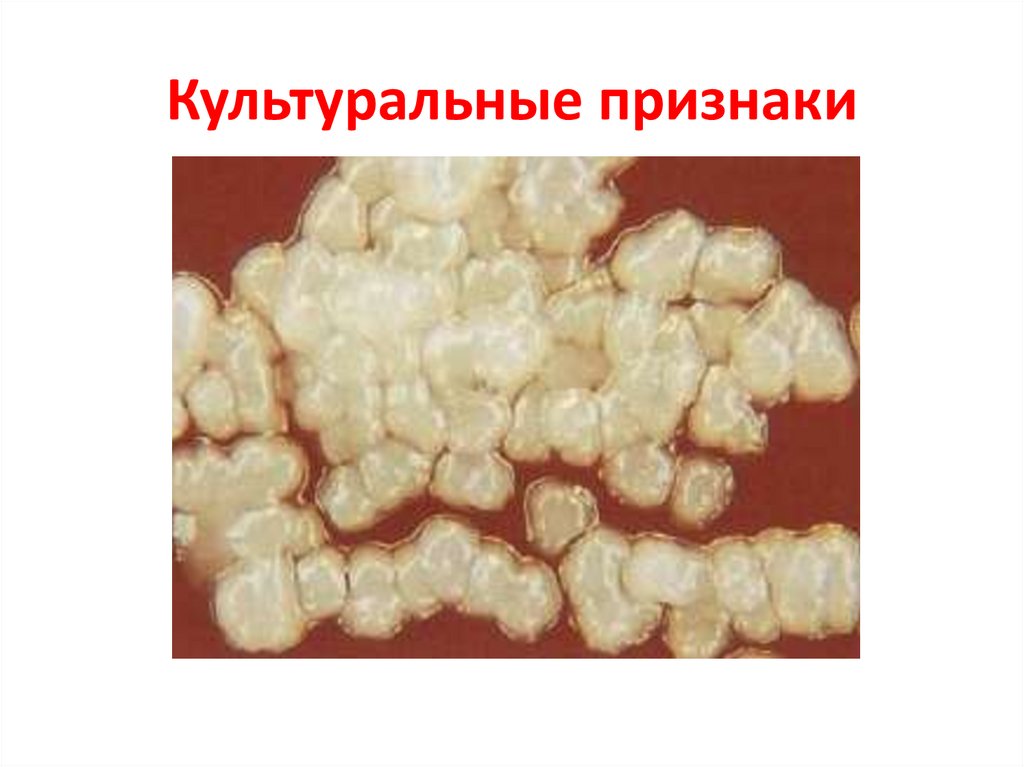

Similar presentations:
Возбудители инфекций верхних дыхательных путей (ВДП), характеризующихся специфичностью патогенеза и клинической картины
1. Возбудители инфекций верхних дыхательных путей (ВДП), характеризующихся специфичностью патогенеза и клинической картины.
Лекция 2Возбудители инфекций верхних
дыхательных путей (ВДП),
характеризующихся
специфичностью патогенеза и
клинической картины.
2. Возбудители туберкулеза = МИКОБАКТЕРИИ – «палочка Коха» - ВК
Возбудители туберкулеза =МИКОБАКТЕРИИ – «палочка Коха» ВК
Семейство: Mycobacteriасеае
Род: Mycobacterium
Виды:
M. tuberculosis
M. bovis
M. africanum
3. Морфологические и тинкториальные признаки «палочки Коха»
Тонкаяпрямая или слегка изогнутая
палочка («швейная игла»);
Не образует:
макрокапсул,
эндоспор,
жгутиков,
но имеет микрокапсулу;
В мазках из патологического материала
располагается одиночно или группами из
2-3 клеток;
Грамположительная (метод окраски
применяется
редко
из-за
плохого
восприятия микобактериями анилиновых
красителей)
4. Отличия микобактерий от других прокариот
• 1. кислото-,спиртощелочеустойчивость,
• 2. высокое содержание в клеточной стенке
липидов (до 60%) и кислот:
-миколовая,
- фтионовая,
- туберкулостеариновая
• 3. очень медленный рост
5. Культуральные свойства палочки Коха
Международная элективная среда = среда ЛевенштейнаЙенсена (включает картофельный экстракт, различныесоли, яйца, глицерин и малахитовый зеленый как агент,
ингибирующий рост контаминирующей микрофлоры),
Оптимальная температура = 37°С,
M. tuberculosis – аэроб,
M. Bovis – микроаэрофил.
- на жидких средах вырастают за 5 - 7 дней – морщинистая
пленка,
- на плотных - в течение 14 - 40 суток - R-формы колоний
(похожие на бородавки или цветную капусту) с желтым
пигментом.
6. Рост микобактерий на среде Левенштейна-Йенсена
7. Биохимические свойства палочки Коха
основнойбиохимический
тест,
используемый для идентификации –
ниациновая проба:
M. tuberculosis –синтезирует
ниацин (никотиновую кислоту),
M. bovis – не синтезирует.
8. Факторы патогенности палочки Коха
• Сульфатиды (серосодержащиегликопротеиды) ,
• Корд-фактор (гликолипид, располагающийся
на поверхности и в толще клеточной стенки),
• Липиды,
• Белки.
9. Туберкулез = первично-хроническое инфекционное заболевание человека и животных, сопровождающееся поражением органов и систем
• хроническое течение,• образование специфических воспалительных изменений,
имеющих вид маленьких бугорков (гранулем),
• преимущественная
локализация
в
легких
и
лимфатических узлах,
• туберкулезная палочка может поражать любой орган и
любую ткань с развитием соответствующей клинической
симптоматики.
• 3 основные клинические формы:
1. Первичная туберкулезная интоксикация у детей и
подростков,
2. Туберкулез органов дыхания,
3. Туберкулез других органов и систем (кожи, костей, почек,
суставов).
10. Эпидемиология туберкулёза
Источник инфекции:Больной человек
Реже - животное
Основной механизм передачи:
Аэрогенный,
Путь – воздушно-пылевой.
Дополнительный механизм (путь) передачи:
алиментарный (заражение M. bovis от крупного
рогатого скота через молоко и молочные
продукты, чаще наблюдается у детей; однако
заражение M. bovis от больных животных
возможно и аэрогенным путем)
11.
Первичный туберкулез либо вовсе не сопровождаетсявыраженной симптоматикой, либо напоминает собой
гриппоподобный синдром.
Вторичный туберкулез - при реактивации инфекции –
наблюдаются (при туберкулезе легких):
• кашель (часто с кровохарканием),
• снижение массы тела,
• обильное ночное потоотделение,
• хронический субфебрилитет.
Многообразие симптоматики туберкулеза делает
его клиническую классификацию достаточно
сложной (разбирается на курсе фтизиатрии)
12. Патогенез туберкулёза
Входные ворота инфекции:дыхательные пути - чаще всего
любые слизистые оболочки
любой поврежденный участок кожи
Фагоцитами доставляется в региональные лимфатические
узлы
Формируется первичный туберкулезный комплекс:
гранулема в месте внедрения возбудителя
воспалительный процесс в региональных
лимфатических узлах
сенсибилизация организма
2 варианта:
13. Патогенез туберкулёза
А. Доброкачественное течение - гранулемыкальцифицируются и рубцуются (у человека
формируется противотуберкулезный иммунитет, но в
гранулеме сохраняется возбудитель).
Б. При действии неблагоприятных факторов, снижающих
антиинфекционную резистентность организма
человека → гематогенная генерализация процесса с
образованием множественных очагов, склонных к
распаду.
14. Инфекционная аллергия при туберкулёзе
• Всегда сопутствует инфицированию туберкулезнойпалочкой.
• Выявляется туберкулиновыми пробами (в
большинстве стран предпочтение отдается
внутрикожному тесту - реакции Манту)
• В качестве аллергена используется:
• туберкулин - фильтрат автоклавированной бульонной
культуры M. tuberculosis.
– очищенный туберкулин (ППД) — purified protein
derivative (PPD) = смесь убитых нагреванием
фильтратов культур МБТ человеческого и бычьего
видов, очищенных ультрафильтрацией.
15. ПРОБА МАНТУ
16. МИКРОБИОЛОГИЧЕСКАЯ ДИАГНОСТИКА ТУБЕРКУЛЁЗА
ПАТОЛОГИЧЕСКИЙ МАТЕРИАЛ(ПРИ ТУБЕРКУЛЁЗЕ ЛЁГКИХ – МОКРОТА)
микроскопия
по Ц.-Н.
обработка кислотой/щёлочью
РИФ
аурамином
засев на среду
заражение м.с.
Л.-Й.
чистая культура
заболевание
идентификация
гибель
определение устойчивости к
препаратам
17. РЕАЦИЯ ИММУНОФЛЮОРСЦЕНЦИИ
18. Культуральный метод
патологический материалсреда
Левенштейна-Йенсена
культивирование – от 2 до 12 недель
идентификация:
ниациновая проба
биопроба
определение чувствительности к
туберкулостатическим препаратам
19. Биологический метод
патологический материалморская свинка
(0,1 мл подкожно в паховую область или в/брюшинно)
лимфоаденит
(5-10 сутки)
положительная реакция на туберкулин
(3-4 неделя)
гибель
(1-2 месяца)
но: изониазидустойчивые штаммы снижают свою
вирулентность для морской свинки
20. Ускоренный метод выделения (метод микрокультур, метод Прайса):
толстые мазки на узких предметныхстеклах обработка 6% серной
кислотой, нейтрализация, промывка
водой
флаконы
с
гемолизированной
цитратной
кровью в разведении 1: 4 через
несколько дней культивирования
окрашивают по Цилю-Нильсену и
микроскопируют:
вирулентные микобактерии
располагаются в виде «лисьих
хвостов» (вследствие наличия в них
корд-фактора),
невирулентные - беспорядочно.
21. Дифференциация M. tuberculosis от M. bovis:
1. Ниациновая проба Конно:культура микобактерий в жидкой питательной среде
+ 1 мл р-ра KCN
+ 1 мл р-ра хлорамина,
через несколько минут:
ярко-желтая окраска - M. tuberculosis
отсутствие её - M. bovis
2. Биопроба - заражение морской свинки и кролика:
Вид
M. tuberculosis
M. bovis
патогенность
для морской свинки
для кролика
+
–
+
+
22. ПРОФИЛАКТИКА ТУБЕРКУЛЁЗА
Неспецифическая- выявление больных = флюорография один
раз в год,
- санитарно-гигиенические мероприятия,
- нормализация условий труда и быта,
-полноценное питание,
- здоровый образ жизни.
23. ПРОФИЛАКТИКА ТУБЕРКУЛЁЗА
СпецифическаяВакцина БЦЖ = BCG - живой ослабленный штамм,
полученный Кальметтом и Гереном из M. вovis,
- вводится внутрикожно.
Вакцинируются дети в возрасте 5 - 7 дней (при ранней
выписке из роддома - на 3 день) жизни.
Ревакцинацию проводят лицам с отрицательной
туберкулиновой пробой.
NB: у новорожденных со сниженной резистентностью
применяют менее реактогенную вакцину BCG-M (с
меньшим содержанием антигена)
24. Этиотропная терапия
• Международный союз борьбы с туберкулезомпротивотуберкулезные препараты по степени
эффективности разделил на 3 группы:
• А – изониазид, рифампицин
(рифапентин,рифабутин,рифатер, рифанг);
• В – стрептомицин, канамицин, этионамид
(протионамид), этамбутол, пиразинамид,
циклосерин, флоримицин, производные
фторхинолонов;
• С – ПАСК (парааминосалициловая кислота),
тиоацетозон (тибон) – в России не применяются.
25. Этиотропная терапия
• Препараты первого ряда: изониазид, этамбутол,стрептомицин, пиразинамид, рифампицин.
• Альтернативные средства: канамицин,
циклосерин, ПАСК (парааминосалициловая
кислота), этионамид, виомицин, капреомицин,
тиоацетазон.
При активной форме туберкулеза назначают до 6
антибиотиков одновременно.
После месячного пребывания в стационаре
больного, как правило, можно выписывать,
однако курс лечения не должен продолжаться
менее года.
26. Возбудитель дифтерии Коринебактерии
Возбудитель дифтерии• Род: Corynebacterium
– C. diphtheriae – возбудитель дифтерии
• var. gravis
• var. mitis
• var. intermedius
27. ДИФТЕРИЯ
• острое инфекционноезаболевание,
основным симптомом
которого является
воспалительный
процесс в верхних
дыхательных путях с
образованием
пленчатых налетов на
слизистой оболочке.
28. Морфологические и тинкториальные свойства
● Грамположительные тонкие палочки среднихразмеров:
var. gravis – короткие,
var. mitis – длинные,
● не образуют макрокапсул и эндоспор,
● располагаются в мазке попарно, под углом друг к
другу.
● Характерны включения зёрен волютина для
выявления которых используют окраску по Нейссеру
(тёмные зёрна на фоне жёлтой цитоплазмы).
29.
30. Культуральные свойства
Растут на сложных питательных средах при 37ОС (насреде Ру – 10-12 ч, на др. средах – сутки).
– жидкие среды: - пленка + осадок (var. gravis)
- муть + осадок (var. mitis)
– среда Ру (свернутая лошадиная сыворотка): колонии не
сливаются (рост в виде «шагреневой кожи»)
– теллуритовые среды (среда Клауберга – кровянотеллуритовый агар):
- серовато-черные R –колонии, похожие на цветок
маргаритки из-за неровного края и радиальной
исчерченности – var. gravis,
- S = мелкие – var. mitis.
31.
32. Биохимические свойства
Для идентификациивида C. diphtheriae:
• цистиназная
активность(проба
Пизу) –
положительная
• уреазная активность
(проба Закса) –
отрицательная
Для идентификации
биовара gravis:
• ферментация
крахмала
• ферментация
гликогена
33. Факторы патогенности
• Токсин (ГИСТОТОКСИН) - основной факторвирулентности дифтерийной палочки (так
как дифтерия вызывается именно
токсином, то её можно считать
токсикоинфекцией)
• ферменты вирулентности:
- Гиалуронидаза
- Нейраминидаза
34. Эпидемиология
Человек (больной илиИсточник инфекции носитель токсигенного
штамма)
Основной механизм Аэрогенный (воздушно(путь) передачи
капельный)
Дополнительный
механизм (путь)
передачи
Контактный (в том
числе и непрямой:
игрушки, молоко)
35.
Клинические проявления:Интоксикация,
фибринозное воспаление в месте
проникновения возбудителя.
Клинические формы:
●Дифтерия зева,
● Дифтерия других органов (кожи, раны,
половых органов и др.).
36. Патогенез:
В месте проникновения образуетсяфибринозная пленка, которая:
= или тесно спаяна с подлежащей тканью (в
месте многослойного плоского эпителия),
= или легко отслаивается от подлежащих
тканей – «дифтерийный круп» (в месте
однослойного цилиндрического эпителия –
в нижних отделах дыхательных путей).
37. Микробиологическая диагностика
Плёнки, слизь из зевамазок
(ориентировочный)
питательные среды
• Ру
• Клауберга
идентификация рода
• зёрна волютина
• культуральные св-ва
идентификация вида
• биохимические св-ва
определение токсигенности
38. Определением токсигенности
• in vivo: заражаютморскую свинку
(подкожно или
внутрибрюшинно), при
вскрытии павшего
животного обращают
внимание на
увеличенные и
гиперемированные
надпочечники,
• in vitro: ставят реакцию
преципитации по
Оухтерлони.
39. Профилактика
НеспецифическаяСпецифическая
• выявление и изоляция • Введение анатоксина (в
том числе входящего в
для лечения больных,
вакцины АКДС и АДС)
• санация
• при необходимости
бактерионосителей,
сохранения
• дезинфекция игрушек,
антитоксического
которыми
иммунитета у взрослых
пользовались больные
необходима
дети.
ревакцинация
анатоксином каждые 10
лет.
40. Этиотропная терапия
антитоксическая сыворотка (её введение
необходимо начинать как можно раньше, пока
токсин не связался с тканью миокарда и нервной
системы),
Антибиотики:
-лактамные,
тетрациклины,
хинолоны;
носителей санируют эритромицином.
Выписка из стационара возможна после
двукратного отрицательного
бактериологического исследования.
41. БОРДЕТЕЛЛЫ – ВОЗБУДИТЕЛИ КОКЛЮША
• Род: BordetellaПатогенные виды:
В. pertussis – вызывает коклюш,
B. parapertussis – вызывает паракоклюш; сходен с
коклюшем, но протекает легче;
B. bronchiseptica –вызывает бронхисептикоз, у
человека встречается редко, в основном у работников
собачьих питомников и кролиководов (этот
микроорганизм вызывает респираторные заболевания
у собак, кошек и кроликов); у человека клинически
протекает как острая респираторная вирусная
инфекция, под этим диагнозом, как правило, и
регистрируется.
42. КОКЛЮШ
— острая антропонозная воздушнокапельная бактериальная инфекция,наиболее характерным признаком которой
является приступообразный
спазматический кашель.
Опасное инфекционное заболевание
дыхательных путей.
43. Морфологические свойства
Окраска по ГрамуФорма
Размер
Эндоспора
грамотрицательные
коккобактерии
отсутствует
Макрокапсула
образуется, но трудно
выявляется
Жгутики
атрихи
Расположение в мазке
беспорядочно
44.
45. Культуральные свойства
Питательные потребностиСложные (среды с кровью или
древесным углем, а также
аминокислотами)
Оптимальная toC
37оС
Условия аэрации
Аэробные
Скорость роста
3 – 5 дней
Селективная питательная среда
На среде Борде-Жангу
(картофельно-глицериновый
агар с добавлением крови) –
мелкие колонии, похожие на
капельки ртути,
На среде КУА (казеиновоугольный агар) – мелкие
сметанообразные колонии
46. Факторы патогенности
Факторы адгезии:- пили – обеспечивают адгезию возбудителя на
эпителиальных клетках,
- филаментозный гемагглютинин и белок наружной
мембраны (пертактин) – склеивают бактерии →
биопленка,
- Капсульные полисахариды – защищают от
фагоцитоза
Токсины - сложное многокомпонентное вещество,
включающее:
- эндотоксин,
- белковый несекретируемый токсин,
- небелковый цитотоксин – производное
пептидогликана клеточной стенки.
47. Действие токсина:
• оказывает местное действие, приводящее врезультате раздражения нервных
рецепторов слизистой оболочки
дыхательных путей к спастическому кашлю
• в результате токсинемии, вызывает:
– возбуждение дыхательного центра,
– спазм мелких бронхов.
48.
Эпидемиология коклюша• Источник инфекции – больной человек (заразен в
течение 1 – 1,5 месяцев болезни)
• Единственный механизм (путь) передачи –
аэрозольный (воздушно-капельный).
Патогенез коклюша – обусловлен:
• воспалительным ответом на размножение
возбудителя (слизистая оболочка гортани,
бронхов, бронхеол и альвеол),
• действием факторов вирулентности B. Pertus.
49. Клинические проявления коклюша
Катаральная стадия (1 – 2 недели):
–
–
Пароксизмальная стадия (2 – 4 недели):
–
–
–
гриппоподобное состояние
слабый, но упорный кашель
спастический кашель
частая рвота
угнетение сознания
Стадия выздоровления (4 – 6 недель):
–
постепенное исчезновение симптомов коклюша.
В настоящее время преобладают (95%) умеренно
выраженные и стертые формы заболевания.
50. Микробиологическая диагностика коклюша
слизь из в/д путейРИФ
питательные
среды
чистая
культура
сыворотка
нарастание
титра Ig
(«парные
сыворотки»)
• РСК
• РНГА
• РА, ИФА
51. Культуральный метод диагностики
Наиболее доказательный, но в последние годывыделение м/о удается редко:
- материал = слизь из верхних дыхательных путей,
- берут с помощью метода «кашлевых пластинок» :
во время приступа кашля ко рту ребенка
подставляют чашку Петри с питательной средой и
ждут на протяжение 6-8 кашлевых толчков;
- или сухим тампоном с задней стенки глотки,
- засевают на питательные среды,
- идентифицируют выделенную культуру по
морфологическим, культуральным,
биохимическим и серологическим свойствам.
52.
53. Дифференциация патогенных видов бордетелл
• подвижность (B. bronchiseptica)• уреазная активность (B. bronchiseptica и B.
parapertussis)
• РА с видоспецифическими сыворотками.
54. Профилактика коклюша
Неспецифическая• Выявление и
изоляция больных
для лечения
Специфическая
• убитая коклюшная
вакцина в составе АКДС
• нормальный
человеческий
иммуноглобулин (при
контакте с больным
детям до года и
неиммунизированным)
55.
Актиномицетысем. Actinomycetaceae
56. Актиномицеты
• вызывают актиномикозы – хроническиегнойные гранулематозные поражения
различных органов.
57. Актиномицеты
• Род: Actinomyces• Виды:
• А. вovis – типовой вид,
• А. israelii – чаще вызывает заболевания,
• А. naeslundii,
• А. odontolyticus,
• A. viscosus.
58. Морфологические признаки
• ветвящиеся бактерии (тонкие палочки с булавовиднымиконцами или нити),
• занимают промежуточное положение между грибами и
бактериями:
- прокариоты, имеют клеточную стенку (КС) как у
грамположительных бактерий, но в отличии от них в
составе КС есть 4 сахара:
- арабиноза,
- галактоза,
- ксилоза,
- мадуроза,
59. Морфологические признаки
- в отличии от грибов не содержат в КС хитина илицеллюлозы,
- не обладают способностью к фотосинтезу,
- грамположительны, но красители удерживают плохо,
- жгутиков не имеют,
- спор не образуют,
- некислотоустойчивые,
- образуют примитивный мицелий.
60. Морфологические признаки
61. КУЛЬТУРАЛЬНЫЕ ПРИЗНАКИ Культуральные признаки
КУЛЬТУРАЛЬНЫЕ ПРИЗНАКИфакультативные или облигатные анаэробы,
• для хорошего роста нуждаются в повышенном
содержании СО2,
• растут на белковых средах, содержащих сыворотку
(на простых средах растут плохо),
• на плотных средах через 24 час образуют
микроколонии - прозрачные бесцветные
паукообразные гладкие, плотно сросшиеся со
средой,
62. КУЛЬТУРАЛЬНЫЕ ПРИЗНАКИ Культуральные признаки
КУЛЬТУРАЛЬНЫЕ ПРИЗНАКИ• через 7-14 суток – макроколонии – бугристые
вросшие в среду белые или окрашенные
(красные, синие), напоминающие коренные зубы,
• на кровяном агаре могут давать гемолиз,
• элективной средой является среда Сабуро,
• оптимальная температура – 37о,
• размножаются только бесполым путем.
63. Культуральные признаки
64. Эпидемиология
• Источник инфекции – почва,• Механизм передачи – контактный,
• Путь передачи – раневой,
• Инфекция может быть как экзогенной, так и
эндогенной (чаще эндогенная),
• Основной предрасполагающий фактор –
снижение сопротивляемости организма,
• Входные ворота инфекции – слизистая оболочка
полости рта или других органов, кожа.
• Инкубационный период – от нескольких суток до
многих лет.
65. Патогенез
• В месте входных ворот образуется воспалительный очаг =гранулема (актиномикома), в которой
обнаруживаются друзы актиномицетов (скопления
мицелия).
• Друзы окружены полиморфно-ядерными лейкоцитами,
- по периферии формируются грануляционная ткань и
фиброзные прослойки,
- имеют радиальную исчерченность,
- их центральная часть состоит из тонкого
густопереплетенного мицелия,
- по периферии обнаруживаются колбовидные утолщения
гиф мицелия.
- Кроме нитей мицелия присутствуют коккопалочки и
палочки.
66. Патогенез
• Позднее гранулема подвергается некрозу собразованием гноя, выходящего через свищи на
поверхность кожи и слизистых оболочек.
Одновременно отмечается фиброз гранулемы.
Затем возбудитель из первичных мест
поражения распространяется по подкожной
клетчатке или соединительной ткани, а также
лимфогенно или гематогенно в ткани с низким
содержанием О2.
• Воспаление обычно распространяется по прямой
по направлению к поверхности кожи.
67. Патогенез
• В пораженных тканях, кроме актиномицетовсодержатся разнообразные бактерии, которые
усиливают течение заболевания:
• - снижая окислительно-восстановительный
потенциал в тканях,
• - создают анаэробные условия,
• - защищают анаэробные актиномицеты за счет
выработки ферментов каталаза и дисмутоксидаза,
• - усиливают низкую инвазивную способность
актиномицетов, выделяя агрессивные ферменты
(гиалуронидазы) и токсины.
68. Клинические формы
1. Актиномикоз лица – наблюдается у 55-60%
всех больных актиномикозами и у 6-10% лиц,
страдающих воспалительными поражениями
челюстей и лица; заболевание протекает
хронически, часто осложняется бактериальными
инфекциями; возможны поражения кожи, мышц,
лимфатических узлов, языка, слюнных желез и
костных тканей.
69. Актиномикоз лица
70. Шейно-челюстно-лицевой актиномикоз
Шейно-челюстно-лицевойактиномикоз
71. Клинические формы
• 2. Абдоминальный актиномикоз - встречается у25-30% всех больных актиномикозами,
первичный очаг – слепая кишка и червеобразный
отросток; часто связана с перфорацией
внутренних органов вследствие аппендицита,
язвенных поражений, дивертикулита,
хирургических или других травматических
повреждений.
72. Клинические формы
3. Торокальный актиномикоз – встречается у 1020% всех больных актиномикозами, часто
отмечаются поражения легких, плевры, реже –
мягких тканей грудкой клетки; возникают в форме
как первичного, так и вторичного поражения.
Вначале заболевание может выглядеть как
бронхит, интерстициальная пневмония, плеврит.
Основные признаки – боль в груди, лихорадка,
кашель с мокротой или без.
73. Клинические формы
• 4. Редкие поражения:• - актиномикоз мочеполовой системы – наиболее часто
связан с применением внутриматочных контрацептивов,
• - актиномикоз костей – возникает как контактно, так и
гематогенно,
• - актиномикоз ЦНС – с развитием менингитов и
менингоэнцефалитов,
• - генерализованный актиномикоз типа
метастазируещего сепсиса.
74. Микробиологическая диагностика
Микробиологическая диагностикаМатериал:
• гной из свищей,
• пунктаты невскрывшихся очагов размягчения,
• соскобы с грануляций,
• мокрота,
• биопсия тканей.
75. Методы микробиологической диагностики
Методы микробиологическойдиагностики
• 1. Микроскопический – обнаружение друз в материале:
• - под малым увеличением видны образования округлой
формы с бесструктурным центром и периферией
радиального строения,
• - под большим увеличением в центре видны сплетения
тонких гиф с пигментированными зернами, по периферии
от этого клубка мицелия отходят в виде лучей гифы с
колбовидными утолщениями на концах.
• По Граму: мицелий фиолетовый, периферия – розовая.
76. Методы микробиологической диагностики
Методы микробиологическойдиагностики
• 2. Микробиологический –
• - для подавления роста сопутствующей микрофлоры гной
или мокроту обрабатывают раствором антибиотиков
(пенициллина и стрептомицина), центрифугируют,
отмывают физ.раствором, центрифугируют
• -осадок засевают на питательные среды (сахарный агар,
среда Сабуро) – 2 чашки: одну культивируют в аэробных,
другую – в анаэробных условиях в течение 2-х недель.
Через 2-3 дня появляются микроколонии, на 10-14 день –
макроколонии. Чистую культуру идентифицируют.
Родовой признак – способность сворачивать и
пептонизировать молоко.
77. Лечение
Лечение1. антибиотики и химиотерапевтические препараты в
высоких дозах не мене 4-6 недель!
- пенициллин,
тетрациклин,
эритромицин,
левомицетин,
хлорамфеникол,
канамицин,
клиндамицин,
ристомицин
2.хирургическое иссечение очагов поражения и
наложение дренажа,
3. специфическая терапия актинолизатом (лучше из
аутоштамма).
78. Профилактика
Профилактика• Специфическая профилактика не разработана,
неспецифическая – повышение иммунного статуса.

medicine
medicine








